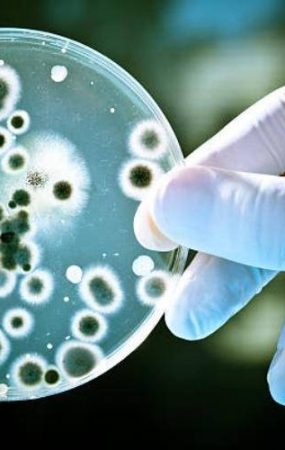

Por que sua empresa deveria apostar na Servitização em Produtos de Limpeza? A venda de produtos de limpeza extrapola os
Bem Estar
Papel Toalha
Papel Higiênico

ABNT NBR: Tudo o que você precisa saber sobre as normas
Quais os parâmentros e métodos de ensaio para a ABNT NBR? A qualidade dos papéis sanitários é um tema de

Papel Sustentável Optipaper: Como escolher a melhor opção?
Quais os diferenciais do papel sustentável? Imagine reduzir o impacto ambiental da sua empresa sem renunciar à eficiência e da

Dispensador de papel toalha e sabonete: como escolher?
Como escolher o melhor dispensador de papel toalha e sabonete líquido para a sua empresa? Higiene, economia e praticidade. Estas

Papel higiênico interfolhado, porque comprar?
Papel higiênico interfolhado – Atualmente temos muitas marcas de papéis sanitários e guardanapos no mercado. Algumas são muito conhecidas e